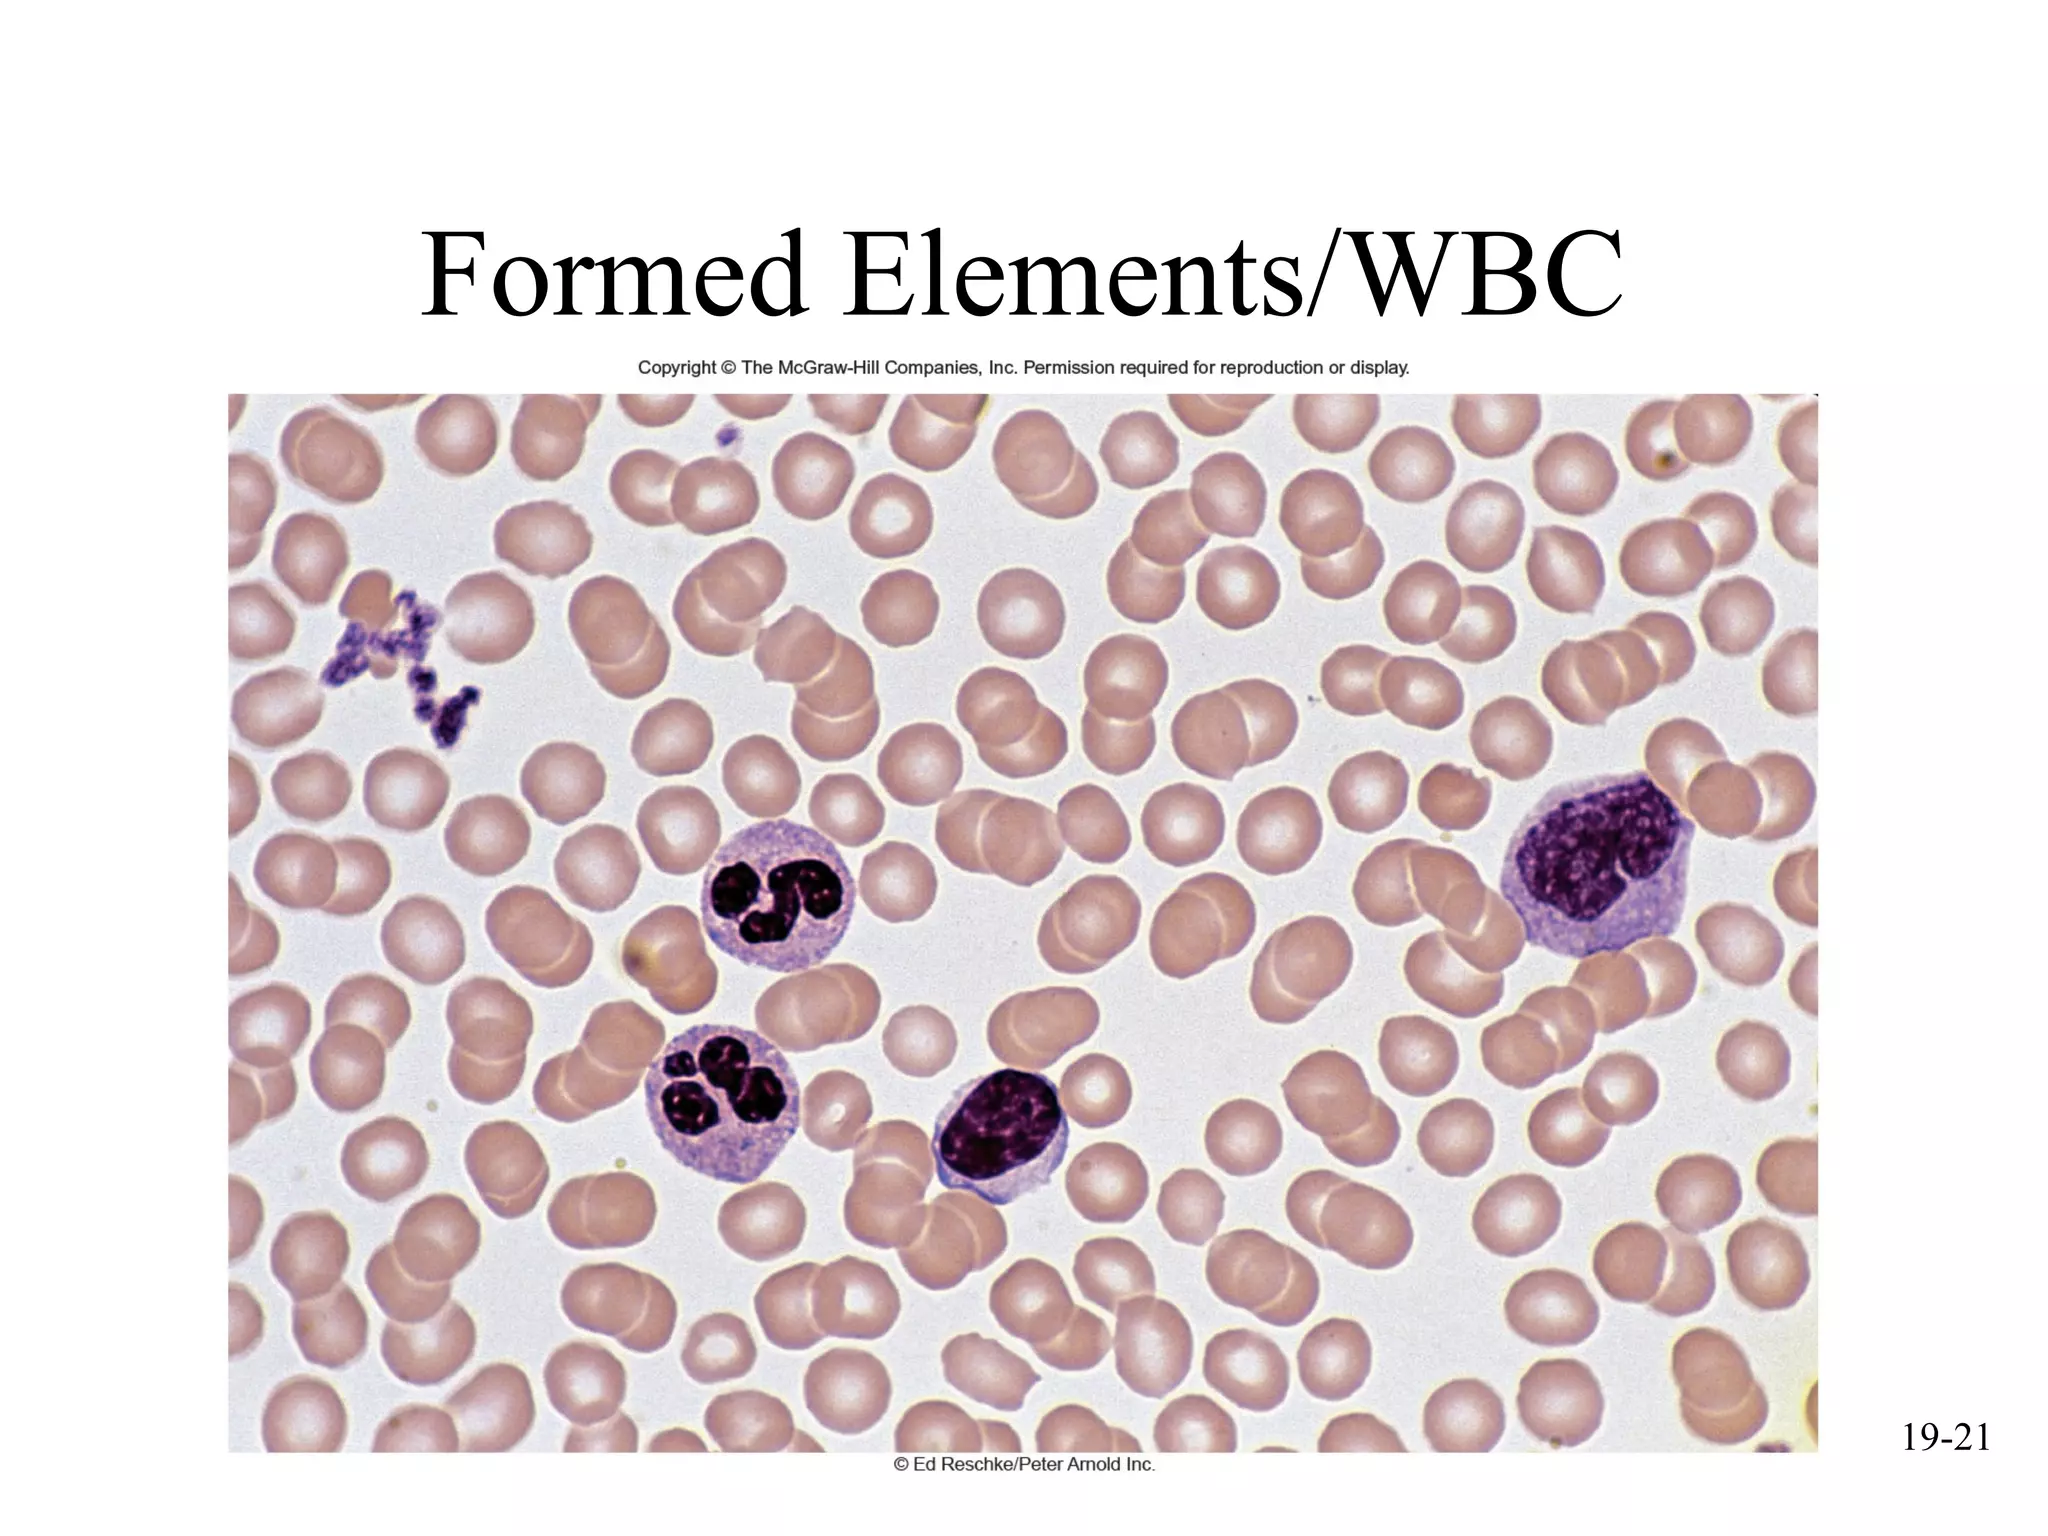
mcgraw hill chapter 19 blood power point | PPT

In addition to the information above, here is a curated collection of images related to Mcgraw Hill Chapter 19 Blood Power Point Ppt.
- Chapter 9 PPT ON BLOOD | PDF | Blood | Blood Type
- PPT - Chapter 19 - Blood PowerPoint Presentation, Free Download - ID ...
- Mcgraw Hill Chapter 19 Blood Power Point | PPT
- Blood PPT | PPT
- PPT - Chapter 19: Blood PowerPoint Presentation, Free Download - ID:4783960
Find More About "Mcgraw Hill Chapter 19 Blood Power Point Ppt"
Explore exclusive offers, detailed information, and related services about mcgraw hill chapter 19 blood power point ppt from our trusted partners.
View Special Offers